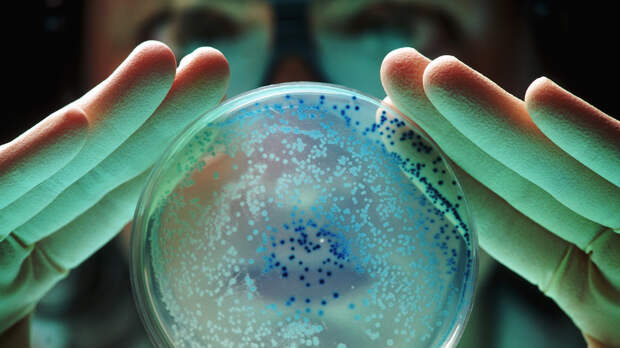

Роскачество проверило мороженое популярных среди россиян торговых марок. В двух сортах продукции была выявлена кишечная палочка.
По данным Роскачества, бактерии обнаружены в мороженом торговой марки «Ермолино» и «Мишка на полюсе».
«Эти бактерии встречаются в продукции, которая не проходит термическую обработку», — отмечается в пресс-релизе ведомства.
Кишечная палочка также может попасть в мороженое в случае нарушения технологии производства или если во время доставки и хранения нарушается целостность упаковки, добавили в Роскачестве.
Всего специалисты проверили 38 торговых марок. При этом некоторые образцы имели признаки фальсификата.
Мороженое «Как раньше», «Ля Фам» и «Филёвское» содержало фитостерин.
«В них же молочного жира оказалось значительно меньше установленных законодательством нормативов, что также подтверждает фальсификацию», — заявили в Роскачестве.
Ранее в ведомстве рассказали, что БАД подлежат обязательной государственной регистрации. При покупке продукции необходимо убедиться, что она имеет соответствующее свидетельство.
Свежие комментарии